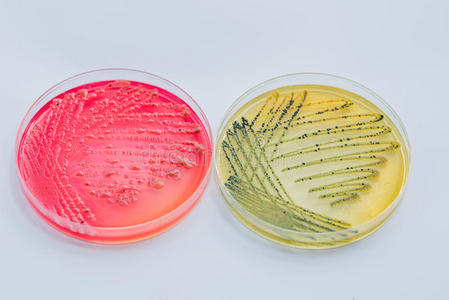
在鉴别和选择性培养基上培养细菌菌落照片

鉴别培养基

大肠杆菌显色培养基
图片尺寸796x1234
鉴别沙门与非沙门菌的两款显色培养基
图片尺寸457x470
木糖赖氨酸脱氧胆盐xld琼脂使用说明,基本培养基配方配制,青岛日水微
图片尺寸670x675
培养基是细菌分离鉴定的常用手段
图片尺寸640x385
1/2ms培养基种拟南芥,十皿里有两皿生长的不正常,根毛特别多,请问是
图片尺寸1872x4032
在鉴别和选择性培养基上培养细菌菌落照片
图片尺寸449x300
ss平板(鉴别/选择培养基)
图片尺寸1080x810
营养培养基.jpg
图片尺寸2848x1728
在鉴别和选择性培养基上培养细菌菌落照片
图片尺寸449x300
微生物培养基的图片
图片尺寸805x2083
鉴定纤维素分解菌的培养基中为什么加土豆汁?
图片尺寸284x292![[樱花r]念珠菌显色培养基(临床商品化)用于念珠菌特别是白色念珠菌和](https://i.ecywang.com/upload/1/img0.baidu.com/it/u=833930252,1750893903&fm=253&fmt=auto&app=138&f=JPEG?w=500&h=666)
[樱花r]念珠菌显色培养基(临床商品化)用于念珠菌特别是白色念珠菌和
图片尺寸1080x1439
尿道定位显色培养基
图片尺寸1000x1000
无菌操作采病死鹅的心血,肝脏分别接种于麦康凯琼脂培养基,伊红美蓝
图片尺寸543x260
500ml bioexplorer(百傲乐)dmem低糖培养基
图片尺寸3024x4032
大肠杆菌o157显色培养基平板大肠杆菌o157显色琼脂培养基
图片尺寸1920x1440
霍乱双糖铁琼脂质控结果:按标签用法制备培养基,接种以下质控菌株
图片尺寸1527x1156
培养基的鉴别培养基
图片尺寸459x341
培养基照片,不断更新中
图片尺寸2816x2112
大肠杆菌/大肠菌群显色培养基(平皿) hbpm7003 9cm*10个/包
图片尺寸796x597